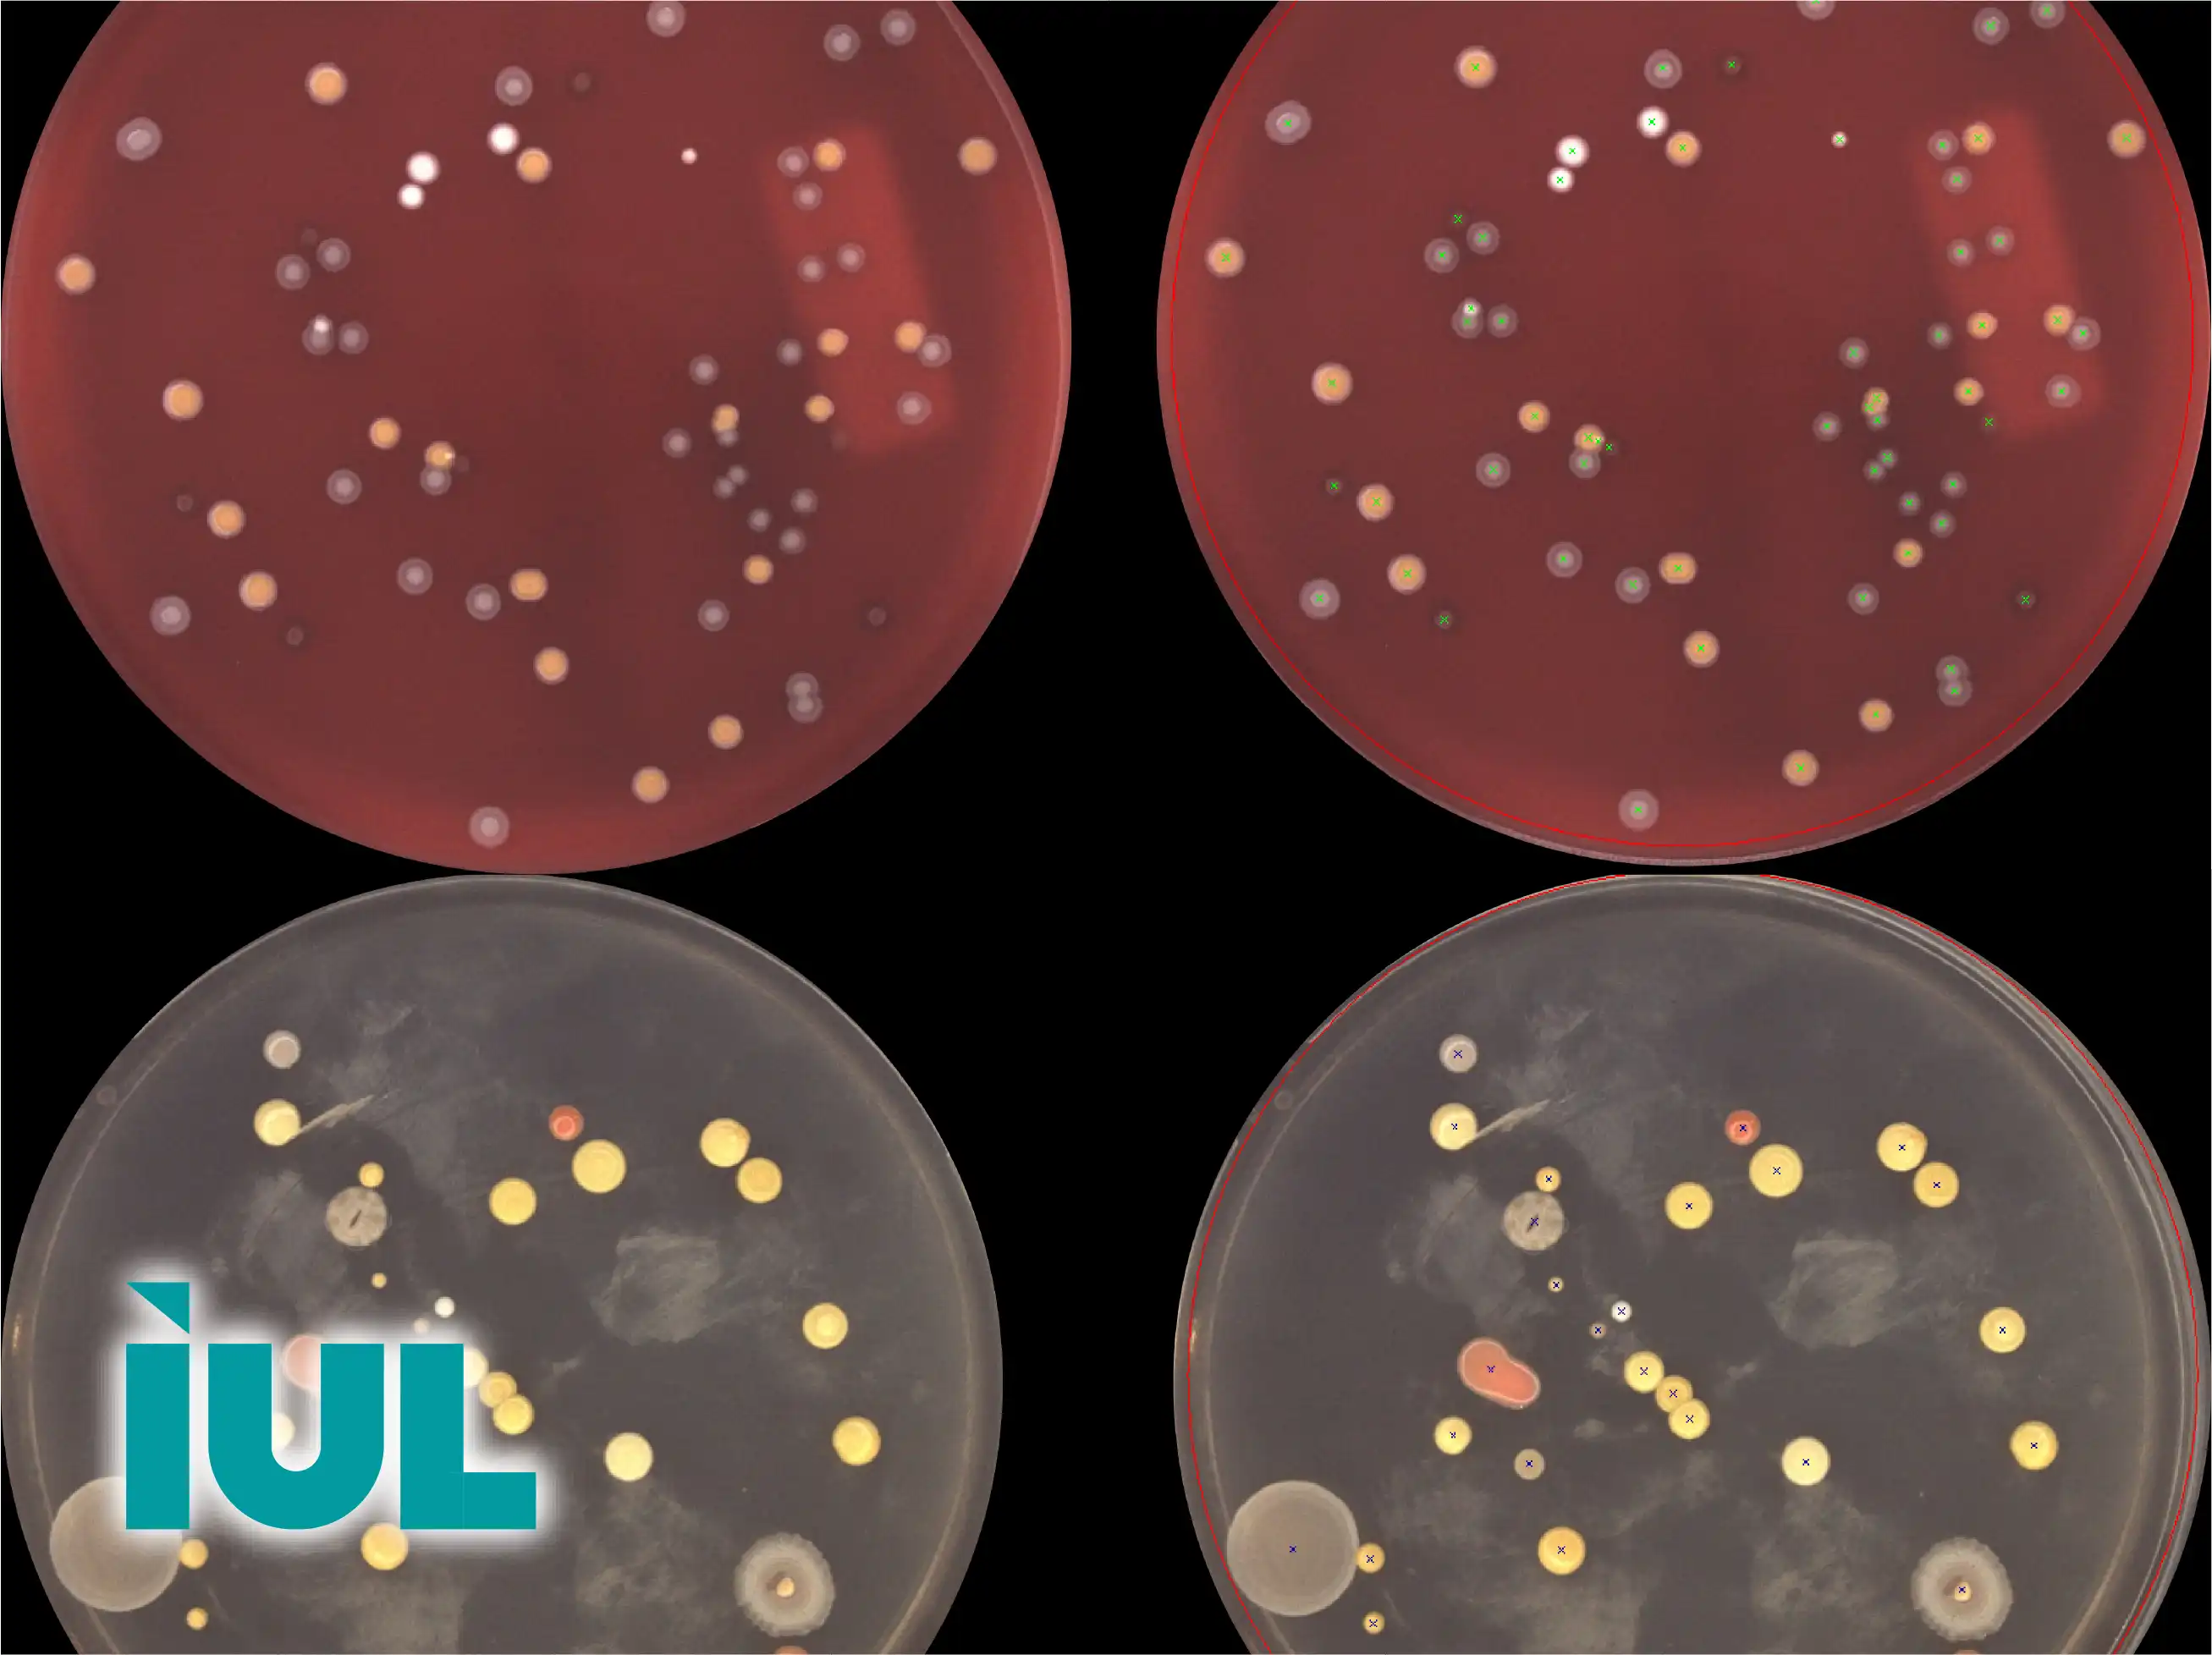
IUL Colony Counting & Zone Reading

Home » Products » Microbiology Laboratory Solutions » Microbiology Testing » IUL Colony Counting & Zone Reading
IUL Colony Counting & Zone Reading
Advanced Solutions for Microbiology
IUL Colony Counting & Zone Reading
Advanced colony counting instruments improve laboratory efficiency by automating repetitive tasks such as plate scanning, colony recognition, and zone measurement. This automation not only increases throughput but also ensures consistent data quality across multiple experiments. By minimizing operator-dependent variability, laboratories can achieve highly reproducible results, essential for regulatory compliance, research studies, and comparative analysis of microbial activity.
Incorporating colony counting with zone reading enables comprehensive microbial analysis, including assessment of antimicrobial susceptibility and detection of contamination patterns. By providing precise measurements of colony size, density, and inhibition zones, laboratories can identify subtle variations in microbial growth and treatment responses. This level of detail supports data-driven decision-making in food safety, pharmaceutical development, and clinical diagnostics, enhancing both research and quality control processes.
Automated Colony Recognition
Advanced colony counting systems use high-resolution imaging and sophisticated detection algorithms to identify colonies of various sizes, shapes, and densities with exceptional accuracy. Even when colonies overlap or are in close proximity, these instruments can distinguish individual units, ensuring precise enumeration for reliable microbial assessment. Accurate colony recognition is crucial for food safety testing, pharmaceutical quality control, and clinical diagnostics.
Precision Zone Measurement
Zone reading capabilities enable precise measurement of inhibition zones around antimicrobial agents or disinfectants. By quantifying the diameter and area of inhibition, laboratories can evaluate microbial susceptibility, optimize treatment protocols, and monitor the effectiveness of sanitation processes. This precise measurement supports research studies, regulatory compliance, and detailed microbial analysis.
High-Throughput Data Acquisition
Automated systems allow simultaneous scanning and analysis of multiple culture plates, significantly increasing laboratory throughput. Fast data acquisition reduces operator workload, minimizes manual counting errors, and ensures rapid turnaround of results in time-sensitive applications such as outbreak monitoring or quality control in production lines.
Reproducible and Standardized Workflows
By following standardized procedures for colony counting and zone measurement, laboratories can achieve reproducible results across different operators and testing sessions. Standardization is essential for regulatory compliance, method validation, comparative studies, and ensuring reliable quality control outcomes in industrial and clinical microbiology laboratories.
Integration with Laboratory Management Systems
Modern instruments can integrate seamlessly with laboratory information management systems (LIMS), enabling automated data storage, retrieval, and traceability. This integration streamlines workflows, reduces documentation errors, and enhances data management capabilities for regulatory reporting and laboratory accreditation purposes.
Support for Diverse Sample Types
These systems accommodate a wide range of sample types, including food, water, pharmaceuticals, environmental swabs, and clinical specimens. Such versatility allows laboratories to conduct comprehensive microbial testing and antimicrobial susceptibility assessments without compromising accuracy or workflow efficiency.
Minimization of Operator-Dependent Variability
By automating critical steps such as colony identification, counting, and zone measurement, instruments reduce human error and operator-dependent variability. This ensures consistent data quality, improves reproducibility across multiple tests, and provides reliable results for scientific research and industrial quality assurance programs.
Enhanced Analytical Insight and Research Applications
Precise colony counting and zone reading allow researchers and quality control personnel to gain detailed insights into microbial behavior, growth patterns, and susceptibility profiles. This information supports data-driven decision-making, helps optimize laboratory procedures, and facilitates the development of new antimicrobial formulations, sanitation strategies, and diagnostic protocols.
Read More About IUL Products Here